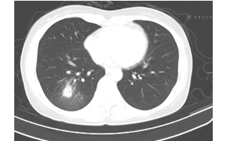

版权归中华医学会所有。
未经授权,不得转载、摘编本刊文章,不得使用本刊的版式设计。
除非特别声明,本刊刊出的所有文章不代表中华医学会和本刊编委会的观点。
麻疹是由麻疹病毒引起的一种传染性极强的疾病,属国家法定的乙类传染病。随着麻疹疫苗的广泛使用,我国麻疹发病率大大降低,但近年来麻疹流行仍时有发生,局部地区甚至出现暴发流行,且流行病学特征发生明显变化,出现周岁内婴儿和成年人两个高发人群[1,2]。成人麻疹的临床表现常不典型,极易漏诊,需要临床医师提高认识。2014年5至7月,吉林大学第一医院及长春市传染病院共收治了21例以肺炎为主要表现的成人不典型麻疹患者,本研究拟通过对这些患者的临床特征进行分析,增强临床医师对此类麻疹的认识。
选择2014年5至7月吉林大学第一医院及长春市传染病院收治的21例以发热和肺炎为主要表现的成人麻疹患者。麻疹的诊断符合文献[3]中的标准,所有患者均经咽拭子核酸检测确诊为麻疹。
连续收集患者的一般资料,包括性别、年龄、麻疹疫苗接种史、近期麻疹患者接触史,患者症状及体征、发疹时间、发热与皮疹关系、肺炎特点、实验室检查结果如血常规、肝功能等。
应用江苏和创生物科技有限公司生产的麻疹和风疹病毒核酸双重检测试剂盒,对麻疹病毒核酸阳性样本,采用荧光定量酶聚合酶链反应(RT–PCR)方法初步确定麻疹基因型。
采用SPSS 17.0统计软件进行数据处理,计量数据以 ±s表示,计数数据用例数和百分率表示。
±s表示,计数数据用例数和百分率表示。
21例患者中,男性15例,女性6例,年龄20~46岁。其中有10例男性患者来自于同一所学校,为聚集性发病,其余11例患者为散发病例,且均否认发热、皮疹患者接触史。21例患者中,14例既往有麻疹疫苗接种史,2例无麻疹疫苗接种史,5例患者接种史不详。
21例患者均有发热,体温多在39~40℃,热程0.5~7 d,平均热程为(4.5±1.7)d。21例患者中19例有皮疹,皮疹出现时间为病程当天1例,第2天1例,第3天3例,第4天3例,第5天4例,第6天6例,第7天1例,平均出疹时间为第(3.6±1.6)d。皮疹均为散在淡红色斑丘疹,无典型麻疹的出疹顺序,皮疹1~2 d内迅速遍及全身。皮疹伴发热的患者在皮疹出现后发热症状很快好转,皮疹出现后3 d内热退,但有4例患者热退后出现皮疹。所有患者均无结膜炎表现及鼻卡他症状。11例患者有轻微咳嗽,咳痰不明显。3例患者口腔有黏膜斑(柯氏斑)。1例患者病程中有一过性轻度腹泻。
12例患者白细胞正常,9例患者白细胞总数降低,最低者为2.2×109/L,均在3 d内恢复正常。16例(76.2%)患者肝功能正常,5例(25.8%)患者肝功能轻度异常(丙氨酸转氨酶<2 ULN)。所有患者咽拭子核酸检测阳性,麻疹病毒基因型为H基因型。
21例患者均行肺电子计算机断层扫描(CT)检查,提示双肺单发(2例)或多发(19例)的斑片状、条片状、团片状、结节状、磨玻璃样高密度影,边界模糊,其中2例病灶中出现含气支气管影。单个病灶直径1~5 cm,可为单肺(9例,其中5例为右肺,4例为左肺)或双肺(12例)受累,在肺叶、段分布上无明显特异性(图1、图2、图3)。






11例散发患者因发热、肺炎住呼吸科、急诊内科及感染科,按肺炎给予抗细菌及抗病毒治疗。患者入院时病程均在4 d~1周,绝大多数患者入院后未再发热(7例患者入院开始即无发热,2例患者入院第2天开始无发热,2例患者入院第3天开始无发热)。因咽拭子核酸检测结果回报周期较长,上述患者未能按麻疹及时进行呼吸道隔离。11例患者中6例在院治疗5~7 d后复查肺CT,均较前次有好转,其余5例患者因无不适症状、状态良好未复查肺CT好转出院;另外10例聚集性发病患者收治于传染病院,给予对症支持治疗,于病程一周以内症状消失,隔离期结束出院,出院后肺CT复查情况不详。
麻疹传染性极强,通过加强麻疹疫苗接种等消除麻疹工作计划后,2005至2013年我国麻疹发病率逐年下降,但是2014年麻疹发病率再次升高。根据我国疾病预防控制中心公布的数据,2014年全年我国麻疹发病数为52 628例,发病率较2013年同期增长90.21%,且成人麻疹患者所占比例明显增加[4]。部分成人麻疹患者因症状不典型,以肺炎、上呼吸道感染等疾病就诊于急诊科、呼吸科等非传染科,造成疾病误诊漏诊,未进行适当隔离,可能成为新的感染源,导致麻疹的传播。
典型麻疹的临床表现为发热、典型皮疹(全身性斑丘疹)、上呼吸道卡他症状、结膜炎和咳嗽。皮疹通常在病程2~4 d出现,从颜面部开始逐渐向下蔓延至全身。临床上根据发热及特征性皮疹、伴咳嗽或鼻卡他症状或结膜炎等作出临床诊断,结合其确切的麻疹患者接触史或实验室证据确诊[3]。有些成人麻疹则因其表现无特异性给诊断带来困难。本研究中的患者均以发热起病,无上呼吸道卡他症状,咳嗽极轻或者无,不伴结膜炎表现,皮疹少,且皮疹特点及出疹顺序不典型,个别患者无皮疹,发病后行肺CT检查提示肺炎,按肺炎诊治,为明确病原体,经咽拭子采样行呼吸道病原体PCR检查才明确麻疹诊断。因此,在现今麻疹流行仍时有发生的形势下,临床上遇成人发热,伴有皮疹的情况,尽管皮疹的出疹时间和顺序与典型麻疹不一致,诊断时仍要考虑麻疹的可能性。
本组病例中,患者年龄主要集中在20~40岁,既往健康情况良好,大部分患者表示既往有麻疹疫苗接种史,但均不能提供末次麻疹疫苗接种时间。患者病程自限,热程均在一周以内,平均热程为(4.5±1.7)d,1例患者仅发热半天。患者发热多在出疹后3 d内迅速退热,状态良好,除肺炎外,其他并发症相对较少且轻,仅1例患者有一过性轻微腹泻,5例患者肝功能轻度异常。患者白细胞计数正常或偏低,提示为病毒性感染。肺炎为本研究中所有患者的主要临床表现,影像学上突出表现为单发或多发的团、片状高密度影,在肺叶、段的分布上无特异性,病灶直径1~5 cm。国内对聚集性流行的不典型麻疹研究发现,成人的肺炎检出率为19.5%~54.9%(经X线检查诊断)[5,6,7],如进行肺部CT检查,则肺炎的检出率则升至31.2%~94.1%[5,7];散发的成人麻疹(包括典型麻疹病例)中肺炎检出率为6.1%~24.1%(经X线检查诊断)[8,9]。国外报道成人麻疹中,肺炎发生率为34%[10]。然而,上述研究显示,不典型成人麻疹患者尽管并发肺炎的概率较高,单个病灶范围可以较大,但咳嗽、胸痛、呼吸困难等症状不重,且病变吸收较快,患者通常一般状态佳,病程自限、预后良好[5,10],本研究结果与之相似。
有研究显示,成人麻疹多表现为不典型的原因可能是麻疹基因变异[6,7,11],然而本组非典型成人麻疹患者感染的麻疹病毒的基因型仍为H型,与近20年来我国所监测到的麻疹流行株一致[12],但其中是否存在某些位点的变异,尚需进一步研究。此外,成人麻疹的非典型表现还可能与患者体内麻疹病毒抗体水平和患者免疫状态有关,但目前关于麻疹的表现与患者体内的麻疹病毒抗体水平以及免疫功能状态的相关性的研究较少,有待进一步研究。